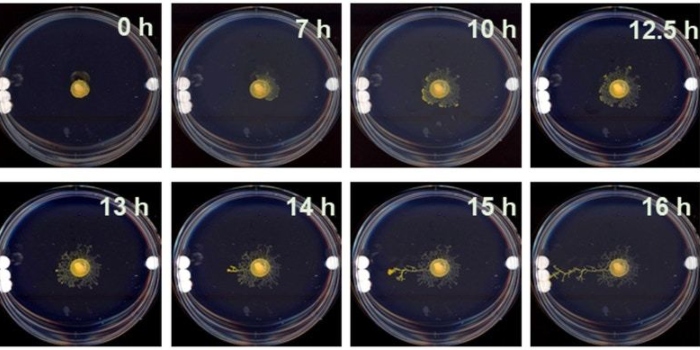

El moho del limo llamado Physarum polycephalum no tiene ningún sistema neuronal en su interior, es como una célula gigantesca que crece. Esta forma de vida parecida a una mancha puede realizar cálculos sorprendentemente complejos, como resolver laberintos o mostrar formas básicas de memoria.
Ciudad de México, 16 de julio (RT).- En un nuevo estudio cuyos resultados fueron publicados en la revista científica Advanced Materials, investigadores del Instituto Wyss de la Universidad de Harvard y del Centro de Descubrimiento Allen de la Universidad de Tufts (EU) pusieron a prueba la conciencia ambiental de un tipo de moho del limo llamado Physarum polycephalum. Es decir, los científicos observaron cómo ese organismo que no posee ni cerebro ni sistema nervioso usa su cuerpo para detectar señales mecánicas en su entorno para realizar cálculos y decidir en qué dirección tiene que crecer.
El Physarum polycephalum es un organismo eucariota que pertenece al reino protista y consiste en un plasmodio, una gran célula única que contiene muchos núcleos celulares que flotan en un líquido citoplasmático.
La autora principal del nuevo estudio, Nirosha Murugan, exmiembro del Centro Allen y profesora asistente en la Universidad de Algoma en Ontario (Canadá), explicó que "la gente se está interesando más en el Physarum porque no tiene cerebro pero aun así puede realizar muchos de los comportamientos que asociamos con el pensamiento, como resolver laberintos, aprender cosas nuevas y predecir eventos".
Aneural organism makes complex decisions, showing evidence of having preferences and creating memories. Mind blown.
— Riddhi J. Pitliya (@RiddhiJP) July 15, 2021
"Averiguar cómo se las arregla la vida protointeligente para hacer este tipo de cálculo nos da más información sobre los fundamentos de la cognición y el comportamiento de los animales, incluido el nuestro", añadió.
A diferencia de estudios previos con el moho del limo, los nuevos resultados se obtuvieron sin dar al organismo ninguna señal química o alimentaria que influyera en su comportamiento. El equipo quería saber cómo el moho toma decisiones en ausencia de estas señales, basándose únicamente en su entorno físico.
"El Physarum no tiene ningún sistema neuronal en su interior, es básicamente una célula gigantesca que crece. Cada vez se está utilizando más al Physarum en el mundo de la cognición porque sus decisiones se pueden leer en su cuerpo", lo que significa que el proceso de "pensamiento" de los organismos se expresa mediante su forma corporal, comentó Murugan a Vice.
Thinking without a brain: Studies in brainless #slimemolds reveal that they use physical cues to decide where to grow @HarvardResearch @advmater https://t.co/Cc8S8VCiLE
— Phys.org (@physorg_com) July 15, 2021
"FUE INESPERADO LO OBVIO QUE ERA"
En su experimento, los investigadores colocaron muestras de Physarum polycephalum en placas de Petri en un gel de agar semiflexible. En un lado de la placa se colocó un pequeño disco de vidrio, mientras que en el otro se colocaron tres discos juntos, uno al lado del otro. Luego dejaron que los organismos crecieran libremente en la oscuridad durante el transcurso de 24 horas y rastrearon sus patrones de crecimiento. Lo que descubrieron fue que durante las primeras 12 horas el moho del limo creció uniformemente en todas las direcciones, pero luego el 70 por ciento de las muestras empezaron a crecer hacia los tres discos en lugar de hacia el disco único.
Los investigadores concluyeron que el organismo podía percibir la mayor tensión producida por el mayor conjunto de objetos que había en la placa, lo que indicaba que ese lado de la placa era una zona que debía explorar preferentemente. "Era realmente obvio que elegían una masa más pesada en un lado. Fue inesperado lo obvio que era; pensé que sería un poco más confuso que eso", dijo Murugan.
Ok mood https://t.co/4nPBEwy7gO
— VICE (@VICE) July 15, 2021
Al mismo tiempo, cuando los tres discos se apilaron uno encima del otro, en lugar de uno al lado del otro, el moho del lodo perdió su preferencia y creció hacia un lado u otro aproximadamente a la misma velocidad. Esto parecía sugerir que no era solo la masa lo que causaba la preferencia del moho por los tres discos situados uno al lado del otro, sino más bien los diferentes patrones de tensión.
La investigación arroja luz sobre la evolución de los organismos aneurales, así como sobre la posible reproducción de sus capacidades en la robótica o las redes neuronales. Las capacidades mecanosensoriales reveladas en el Physarum polycephalum son también similares a las de las células somáticas, incluidas las neuronas, por lo que pueden contribuir al estudio del funcionamiento del cerebro.